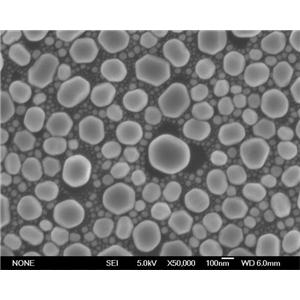

6YR企业会员
 纳米二氧化硅;气相白炭黑;亲水型二氧化硅
纳米二氧化硅;气相白炭黑;亲水型二氧化硅
¥400 元
更新时间:2026/04/14
 3D打印球形钽粉
3D打印球形钽粉
¥725 元
更新时间:2026/04/14
 3D打印球形铌粉;超细铌粉;高纯铌粉
3D打印球形铌粉;超细铌粉;高纯铌粉
¥595 元
更新时间:2026/04/14
 3D打印球形钨粉;超细钨粉
3D打印球形钨粉;超细钨粉
¥400 元
更新时间:2026/04/14
 3D打印球形钼粉;喷涂钼粉
3D打印球形钼粉;喷涂钼粉
¥500 元
更新时间:2026/04/14
 3D打印球形钛粉
3D打印球形钛粉
¥450 元
更新时间:2026/04/14
 微纳米铬粉;超细铬粉;电解金属铬
微纳米铬粉;超细铬粉;电解金属铬
¥575 元
更新时间:2026/04/14
 雾化法球形锡粉;微纳米锡粉;高纯金属锡粉
雾化法球形锡粉;微纳米锡粉;高纯金属锡粉
¥495 元
更新时间:2026/04/14
纳米铟粒子;球形铟粉;高纯金属铟
纳米铟粒子;球形铟粉;高纯金属铟
¥750 元
更新时间:2026/04/14
 纳米铋粉;球形铋粉;高纯金属铋
纳米铋粉;球形铋粉;高纯金属铋
¥595 元
更新时间:2026/04/14
 纳米铅粉;超细黑铅粉;高纯金属铅
纳米铅粉;超细黑铅粉;高纯金属铅
¥525 元
更新时间:2026/04/14
 50nm二氧化锆 钇稳定纳米氧化锆
50nm二氧化锆 钇稳定纳米氧化锆
¥300 元
更新时间:2026/04/14
 碳纳米管垂直阵列
碳纳米管垂直阵列
¥360 元
更新时间:2026/04/14
 羧基化双壁碳纳米管
羧基化双壁碳纳米管
¥460 元
更新时间:2026/04/14
 羧基化多壁碳纳米管
羧基化多壁碳纳米管
¥400 元
更新时间:2026/04/14
 单壁碳纳米管
单壁碳纳米管
¥600 元
更新时间:2026/04/14